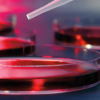

American Medical Seminars Family Medicine & Women’s Health 2025 (Videos + Audios + Syllabus)
$82
Secure CheckoutEncrypted payments—shop with confidence
Google Drive AccessPrivate link to your digital course files
High-Yield Study ContentConcise CME & Board Review resources
Responsive Email SupportHelpful answers for orders & downloads
American Medical Seminars Family Medicine & Women’s Health 2025 (Videos + Audios + Syllabus)
Include: 4 videos 4 audios 1 pdf, size: GB
The American Medical Seminars Family Medicine & Women’s Health 2025 conference is scheduled for March 17–20, 2025, in Sarasota, Florida. It offers a comprehensive update on family medicine and women’s health topics, with expert-led sessions and continuing medical education (CME) credits.
Key Details
- Location: Sarasota, Florida.
- Format: Live event and webinar.
- Topics Covered:
- Contraception and menopause management.
- Breast and gynecologic cancer screening.
- STI treatments and updates.
- Diagnosis and treatment of recurrent headaches.
- Evaluation of ischemic heart disease in women.
The American Medical Seminars Family Medicine & Women’s Health 2025 conference is designed for healthcare professionals specializing in family medicine and women’s health. The target audience includes:
- Primary Care Physicians: Those managing a broad range of family medicine and women’s health concerns.
- Obstetricians & Gynecologists: Specialists in reproductive health, contraception, and menopause management.
- Nurse Practitioners & Physician Assistants: Supporting roles in outpatient and primary care settings.
- Medical Researchers & Educators: Professionals focused on advancing clinical knowledge in family medicine and women’s health.
The event provides continuing medical education, expert-led sessions, and updates on gynecologic cancer screening, STI treatments, contraception, and more.
Topics:
| Date | Session | Time | Speaker | Topic | Topic # |
| 3/17/2025 | 1-1 | 7:30am-8:30am | Muncie | Anemia – A Finding, Not Yet a Diagnosis. | 15 |
| 1-2 | 8:35am-9:35am | Nelson | Contraception | 330 | |
| 1-3 | 9:40am-10:40am | Nelson | Diagnosis and Treatment of Heavy Menstrual Bleeding | 331 | |
| 1-4 | 10:45am-11:45am | Ninia | Chronic Venous Insufficiency | 589 | |
| 1-5 | 11:50am-12:50pm | Ninia | Pelvic Phlebology | 590 | |
| 3/18/2025 | 2-1 | 7:30am-8:30am | Ninia | Pelvic Pain and Endometriosis | 591 |
| 2-2 | 8:35am-9:35am | Ninia | Office Urogynecology | 593 | |
| 2-3 | 9:40am-10:40am | Nelson | Perimenopause and menopause | 333 | |
| 2-4 | 10:45am-11:45am | Nelson | Breast cancer screening and prevention | 334 | |
| 2-5 | 11:50am-12:50pm | Muncie | Treatment of depression and anxiety in primary care | 18 | |
| 3/19/2025 | 3-1 | 7:30am-8:30am | Nelson | GYN cancer screening and prevention | 335 |
| 3-2 | 8:35am-9:35am | Nelson | STI Treatments and Update | 336 | |
| 3-3 | 9:40am-10:40am | Ninia | Ultrasound in OB/Gyn | ||
| 3-4 | 10:45am-11:45am | Ninia | Osteoporosis Understood | 594 | |
| 3-5 | 11:50am-12:50pm | Muncie | Diagnosis and treatment of recurrent headaches – migraine, tension, cluster | 21 | |
| 3/20/2025 | 4-1 | 7:30am-8:30am | Muncie | Evaluation and treatment of ischemic heart disease in women | 25 |
| 4-2 | 8:35am-9:35am | Ninia | Vaginitis Revisited | 595 | |
| 4-3 | 9:40am-10:40am | Ninia | Cervical Dysplasia and the abnormal pap | 610 | |
| 4-4 | 10:45am-11:45am | Nelson | The Role of Primary Care Providers in Reducing Maternal Mortality | 629 | |
| 4-5 | 11:50am-12:50pm | Nelson | PCOS | 332 |
Tags: abnormal pap smear, American Medical Seminars 2025, american medical seminars audios, american medical seminars cme, American Medical Seminars Conference, American Medical Seminars Family Medicine, american medical seminars florida, american medical seminars sarasota, american medical seminars syllabus, american medical seminars videos, american medical seminars women’s health, AMS CME 2025, AMS CME audios, AMS CME syllabus, AMS CME videos, AMS education, AMS Family Medicine, AMS Medical Conference, AMS Sarasota, AMS Women’s Health, anemia diagnosis, anxiety in primary care, breast cancer prevention, breast cancer screening, cervical dysplasia, chronic disease management women, chronic venous insufficiency, clinical gynecology updates, clinical updates family medicine, clinical updates women’s health, cluster headache management, CME audios, CME Conference 2025, CME conference Sarasota 2025, CME Credits, CME for family medicine, CME for nurse practitioners, CME for OB/GYN, CME for physician assistants, CME for Physicians, CME for Primary Care, CME for women’s health, CME live event, CME pdf family medicine professionals, CME Sarasota Florida, CME syllabus, CME syllabus 2025 American Medical Seminars, CME Videos, CME videos and audios 2025, CME webinar, continuing medical education family medicine, continuing medical education women’s health, contraception management, contraception updates, depression in primary care, endometriosis management, endometriosis treatment, expert-led medical sessions, family medicine and women’s health CME 2025, Family Medicine CME, Family Medicine Conference 2025, family medicine professionals, family medicine seminar 2025, family medicine update 2025, Family Medicine Updates, gyn cancer screening, gynecologic cancer prevention, gynecologic cancer screening, gynecologists, Gynecology CME, gynecology conference, healthcare conference 2025, healthcare professionals, healthcare providers American Medical Seminars Family Medicine & Women’s Health 2025, heavy menstrual bleeding, ischemic heart disease in women, live medical conference, maternal health cme, maternal health updates, maternal mortality reduction, medical conference audios, medical conference syllabus, medical conference videos, medical education family medicine, medical education for educators, medical education for nurse practitioners, medical education for obgyn, medical education for physician assistants, medical education for physicians, medical education for researchers, medical education women’s health, medical educators, medical researchers, medical seminar Sarasota, menopause management, menopause updates, migraine treatment, nurse practitioners, OB/GYN ultrasound, obgyn professionals, obstetricians, obstetrics cme, obstetrics conference, office urogynecology, osteoporosis management, outpatient gynecology, outpatient women’s health, PCOS management, pelvic pain, pelvic pain management, pelvic phlebology, perimenopause care, physician assistants, polycystic ovary syndrome, preventive women’s health, primary care physicians, primary care professionals, Primary Care Updates, primary care women’s health, recurrent headache management, reproductive endocrinology cme, reproductive health cme, sarasota medical conference, Sarasota medical conference 2025, STI treatment updates, tension headache treatment, ultrasound in ob/gyn, vaginitis management, vaginitis treatment, webinar medical conference, Women’s Health CME, women’s health conference 2025, women’s health professionals, women’s health seminar 2025, women’s health specialists, women’s health update 2025, women’s health updates